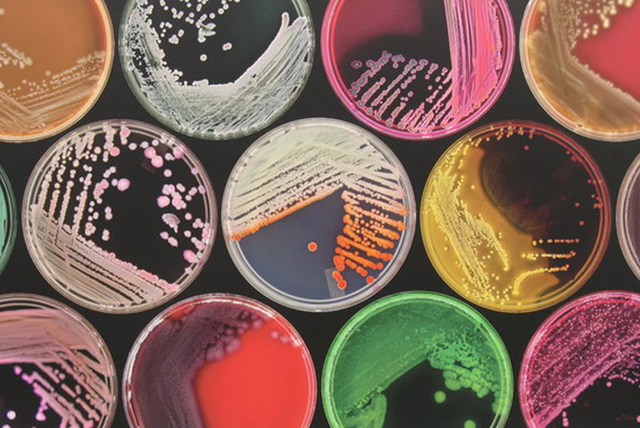
Fundación de la bacteriología
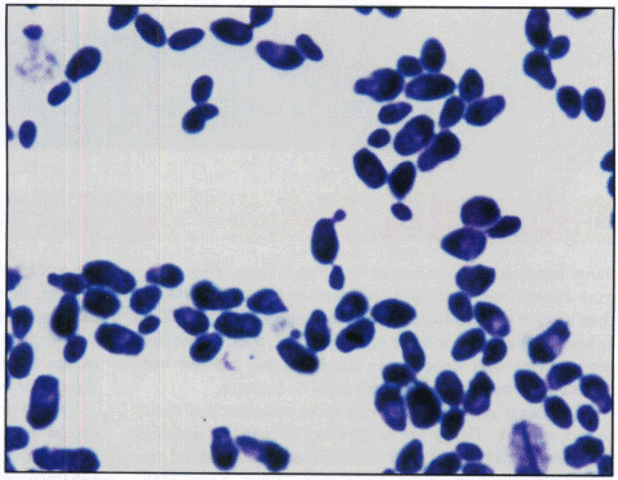
Fotografías de bacterias
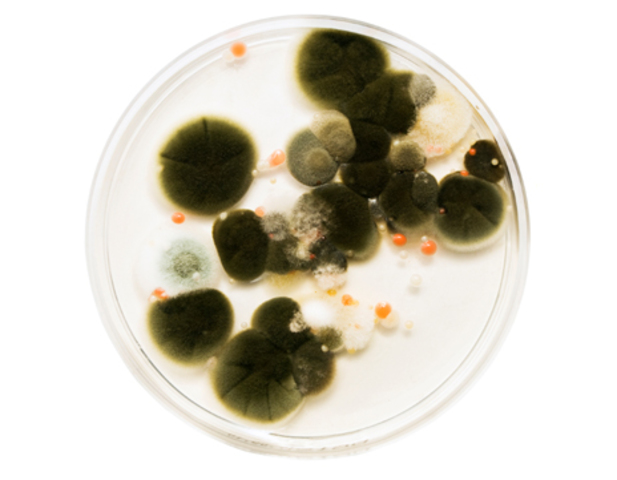
Antifungico nistatina
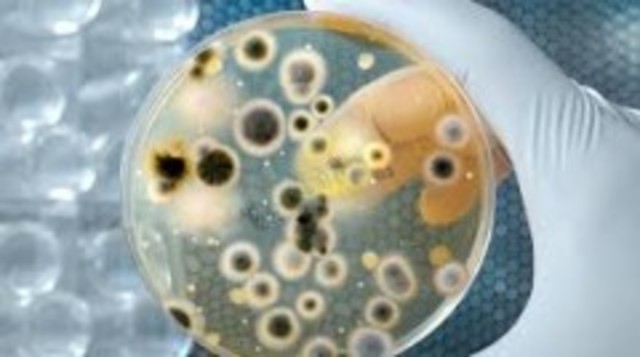
Gripe Aviar

-
Inician los primeros brotes de viruela en asentamientos del este africano
-
Egipcios y Sumerios desarrollan los primeros productos derivados del proceso de fermentación (pan y cerveza), sin embargo se desconoce el mecanismo y la razón de este fenómeno
-
Escrita por Marco Terencio Varrón la obra se antepone a la microbiología. El autor alerta sobre la presencia de criaturas que no se pueden ver, pero que flotan en el aire, entran al cuerpo por la boca causando enfermedades graves, recomienda alejarse de los pantanos y marismas, donde el piensa estos habitaban
-
"Kitab fi al-jadari wa-al-hasbah", obra elaborada por el médico persa Al-Razí, donde además se propone la primera teoría de la inmunidad
-
Desarrolladas en China por monjes taoístas a petición del ministro Wang Dan
-
Se diseminará por toda Europa matando a un tercio de la población de Europa (75 millones de personas)
-
La ciudad de Kaffa bajo control Genoves es asediada por mongoles, catapultando cadáveres infectados con peste bubónica sobre las murallas
-
Escrito por Girolamo Frascatoro, el tratado propone una teoría sobre el origen de las enfermedades contagiosas, que son causadas por seres invisibles.
-
Inventado por Zacharias Janssen fabricante de lentes holandés
-
Robert Hooke corta un pedazo de corcho, en el cual descubre pequeños espacios parecidos a celdillas de un panal, de ahí el nombre de célula
-
Francesco Redi demuestra que la carne en putrefacción por si sola no puede generar gusanos atestando un fuerte golpe contra la teoría de la generación espontanea
-
Anton van Leewenhoek descubrió a los organismos (animalculos) observándolos en gotas de aguas de un lago con la ayuda de un microscopio casero
-
Lady Mary Wortley Montegu en su regreso de Turquia a Inglaterra, lleva consigo el procedimiento de variolización inocula a sus hijos, y divulga el procedimiento.
-
Lazzaro Spallanzani en su experimento cuece caldos en recipientes sellados, los caldos no generan microorganismos, desechando la hipótesis de la generación espontanea
-
Edward Jenner prueba su vacuna en un niño de 8 años James Philips, obteniendo resultados exitosos
-
Agostino Bassi lo descubre, describe la forma de eliminarlo y prevenirlo. Se refuerza así la teoría de que las enfermedades son ocasionadas por agentes infecciosos.
-
Theodor Schwann demuestra que la putrefacción y la fermentación es realizada por microorganismos.
-
François Appert. Desarrolla el método de esterilización de alimentos envasados conocido como appertización.
-
Estudia la naturaleza de las levaduras el proceso de fermentación alcohólica y la influencia del frío extremo en sus vidas.
-
Mathias Schleiden y Theodor Schwann proponen de manera independiente que todos los organismos estan compuestos por células, la unidad básica de la vida
-
J. Henle proporciona las bases para el desarrollo de la teoría germinal de la enfermedad
-
MIles Josheph Berkeley descubrió un hongo (phytophtora infestans) que produce la podredumbre de la patata
-
Ignacio Felipe Semmelweis consiguió disminuir drásticamente la tasa de mortalidad en un 70 % por sepsis puerperal entre las mujeres que daban a luz en su hospital mediante la recomendación a los obstetras de que se lavaran las manos con una solución de cal clorurada antes de atender los partos.
-
John Snow realiza el primer estudio epidemiológico del cólera en Londres donde plantea que ésta se transmitía mediante
la ingestión de una “materia mórbida” invisible al ojo humano, la cual debía actuar a nivel de los intestinos, y que había
de reproducirse y eliminarse a través de las deposiciones, las cuales, finalmente, terminaban en aguas del Támesis. -
Louis Pasteur observó que se producía más alcohol en ausencia de oxígeno cuando se fermenta el azúcar, introdujo los términos aeróbico y anaeróbico en la descripción del crecimiento de la levadura a expensas del azúcar en presencia o ausencia de oxígeno.
-
Demuestra Pasteur gracias a sus matraces de cuello de cisne que una célula siempre proviene de otra célula progenitora
-
Heinrich Anton deBary noculó esporas de P. infestans en papas sanas y observó la penetración y el posterior crecimiento del micelio que afectó al tejido, la formación de conidios. De todos sus estudios, concluyó que los organismos no podían ser generados espontáneamente.
-
Louis Pasteur desarrolla la pasteurización como método para destruir organismos no deseados en el vino
-
En dos años mueren 500.000 cabezas de ganado. Las investigaciones gubernamentales sobre la enfermedad suscitan testimonios que ilustran con cierta profundidad las opiniones contemporáneas sobre la epidemiología y la teoría de los gérmenes de la enfermedad.
-
Joseph lister antisepticos y desarrolla el principio de la asepsia en la práctica quirúrgica: Primero aplicaba compresas de agua fenicada y después pulverizaba el ambiente y los objetos que podían entrar en contacto con la herida completándolo con el uso de pomadas fenicadas
-
El discurso de Thomas H. Huxley ofreció un poderoso apoyo a la afirmación de Pasteur de haber rechazado experimentalmente la generación espontánea
-
Ernst haeckel creó un taxón denominado "Moneres" para agrupar las bacterias, es el precursor de la división entre los seres procariotas y eucariotas
-
Ferdinand J. Cohn contribuye a la fundación de la ciencia de la bacteriología. En la publicación Ueber Bakterien, él discute el papel de microorganismos en el ciclo de elementos en naturaleza.
-
El botánico alemán Brefeld reportó el crecimiento de colonias fúngicas de esporas individuales sobre superficies de gelatina. Antes de esta innovación que resultó en el aislamiento del cultivo puro de microorganismos, colonias bacterianas pigmentadas fueron aisladas por el biólogo alemán Schroeter sobre rodajas de papa incubadas en un ambiente húmedo.
-
Gerhard Henrik Armauer Hansen describió cómo observó a Mycobacterium leprae, como "cuerpos en forma de varilla" después de cortar un nódulo de lepra, raspar el borde del corte con un cuchillo y frotar el material sobre un portaobjetos de vidrio. Demostró claramente que estas varas representaban el origen infeccioso de la lepra. Esta es la primera vez que se demuestra que una enfermedad infecciosa crónica en seres humanos está relacionada con un bacilo.
-
Cohn publica una clasificación temprana de las bacterias, usando el nombre del género, Bacillus, por primera vez.
-
Robert Koch publica un artículo sobre su trabajo con el ántrax, señalando explícitamente a una bacteria como la causa de esta enfermedad. Esto valida la teoría germinal de la enfermedad.
-
descubrió las esporas bacterianas y relacionó su resistencia a los procesos de esterilización.
-
John Tyndall desarrolla la esterilización por calentamiento discontinuo, evidenció la existencia de formas microbianas muy resistentes al calor
-
Robert Koch seca las películas de bacterias, las mancha con azul de metileno y luego las fotografía. Utiliza cubiertas para preparar registros visuales permanentes.
-
Demuestra por primera vez una enfermedad bacteriana de las plantas; El micrococcus amilóforo causa el tizón de la pera.
-
Publica su estudio de la fermentación láctica de la leche, demostrando la causa específica de la acidez de la leche. Su investigación se lleva a cabo utilizando el primer método desarrollado para aislar un cultivo puro de una bacteria, al que nombra Bacterium lactis.
-
Trabajó sobre el parásito de ratas indias (Trypanosoma lewisi), cuya importancia se realizó después de que Griffith Evans (1880) descubriera el tripanosoma patógeno en caballos y camellos en la India (Trypanosoma Evansi)
-
Heinrich Anton deBary acuñó el término simbiosis en su monografía "Die Erscheinung"
-
inventa vacuna contra el virus de la rabia
-
Surgimiento del agar-agar.
-
Crecimiento de bacterias en medios solidos
-
Descubre el Mycobacterium tuberculosis. Y se determinan sus postulados.
-
Estudió a la bacterias del azufre y nitrificantes.
-
Descubrimiento
-
Agente causal del tétano descubierta por Shibasaburo Kitasato
-
Pionero en el campo de la patología vegetal descubre que "la plaga de fuego"de los árboles frutales es causada por una bacteria.
-
-
Desarrollo del método
-
-
-
Agente causal de la brucelosis en el ganado
-
Obtuvo un cultivo puro de la bacteria Rhizobium de los nodulos de las raices y estudió el proceso de fijación del nitrógeno.
-
Tuvo avances probablemente tan importantes como R. Koch o L. Pasteur pero no impactaron tanto como los de medicina, ya que se dedico a la microbiologia de agricultura e industrial.
-
En 1890, Emil von Behring luego de sus éxitos en la lucha contra el tétanos, se concentró en hacer experimentos en casos con difteria. Con Fraenkel y Kitasato inyectó toxina diftérica a cobayas y, luego, les inyectó suero de animales que habían sobrevivido a la enfermedad. El suero de animales inmunes podía curar a los expuestos a la toxina, por lo que Behring concluyó que la inmunidad natural reside en los líquidos e inició la teoría humoral de la inmunidad.
-
Fue un biólogo ruso y el primer científico en descubrir los virus. Observó una enfermedad en la planta del tabaco y que era causada por un agente infinitamente minúsculo capaz de impregnar los filtros de la porcelana, algo que las bacterias nunca podrían hacer.
-
Observó presencia antimicrobiana en contra de Vibrio cholerae en aguas del rio Ganges y Jumma en la India. La presencia se trataba de los bacteriófagos aunque en un principio no supo que eran. Evitó la propagación.
-
Describen el agente causante de la glosopeda. Aislamiento de virus en animales.
-
Reconoció la dependencia de las células virales para su reproducción.
-
Por Harry Plotz
-
Descubrió el Salvarsan, el primer tratamiento medicinal eficaz contra la sífilis, iniciando y dando nombre al concepto de quimioterapia. Ehrlich popularizó en medicina el concepto de bala mágica, como un producto específico capaz de eliminar por completo un determinado organismo patógeno sin efectos secundarios relevantes.
-
Por Francis Peyton Rous
-
Por Félix d’Herelle. Descubre el bacteriófago, "un microbio invisible, antagónico del bacilo de disentería".
-
Una cepa mutada de H1N1 ocasiona la pandemia más mortífera de la historia “la gripe española matará entre el 3 y 6% de la población mundial ( 50-100 millones
-
Por Félix d’Herelle. Primer intento de terapia fágica, uso fagos para tratar la disentería. Tuvo éxito pero no fue publicado inmediatamente.
-
Richard Bruynoghe & Joseph Maisin hacen el primer uso de bacteriófagos oficial, para tratar la enfermedad estafilococia de la piel.
-
Frederick Griffith descubre la transformación genética en bacterias, y con eso surge una pregunta clave en genética: ¿Qué químico causó la transformación?
-
Por Alexander Fleming, descubre la penicilina el antibiótico más utilizado en el mundo.
-
Por Minoru Shirota. Es una especie de bacteria anaeróbica de origen intestinal, productora de ácido láctico, se emplea en la industria láctea en la elaboración de alimentos probióticos.
-
Para los humanos
-
Entre Francia y USA. Pero esta produccion cesó en el occidente por los antibioticos.
-
Por Selman Waksman que describió la producción de los antibióticos actinomicina, estreptotricina, cicloserinas y novobiocina por actinomicetos.
-
Por Max Delbruck. Descubrimientos relacionados con los mecanismos de replicación y estructura genética de los virus.
-
Joshua Lederberg y Edward Lawrie Tatum demuestran la existencia de conjugación en Escherichia coli.
-
André Michel Lwoff estudia el fenómeno de la lisogenia
-
Elizabeth Hazen and Rachel Brown descubren el antifúngico nistatina
-
Alfred Hershey y Martha Chase demuestran que el DNA era el material genético de algunos virus.
-
Joshua Lederberg introduce el concepto de plásmido
-
Jonas Salk desarrolló la primera vacuna contra la polio
-
Rene Dubos trabaja en agentes antimicrobianos y protección ambiental
-
François Jacob y Jacques Monod proporcionan el primer ejemplo de control de la expresión de genes a nivel de transcripción: modelo del operón
-
Se descubren los elementos transponibles en bacterias.
-
Theodor Diener demuestra las diferencias fundamentales entre viroides y virus
-
Primer uso comercial de un sistema de biorremediacion para limpiar un derrame de Sun Oil pipeline en Ambler, Pennsylvania
-
Woese y George E. Fox reconocen las archeas como el tercer dominio de los seres vivos.
-
Luc Montaiger y Robert Gallo de manera independiente descubrieron, aislaron y caracterizaron el virus de la inmunodeficiencia humana (VIH)
-
Clements y Bullivant descubren Epulopiscium fishelsoni, la mayor célula procariota.
-
Organismo "Haemophilus influenzae"
-
Secuenciación del genoma de este organismo
-
Un equipo británico descubre que los virus porcinos pueden infectar células humanas.
-
Completado el mapa genético de la bacteria 'E. coli', la más conocida y utilizada en biología
-
Un grupo de científicos alemanes, americanos y españoles, descubren en Namibia la mayor bacteria conocida hasta ahora.
-
Heidelberg y col. completaron el genoma de la bacteria gram negativa, gamma-Proteobacterium Vibrio cholerae, y descubrieron que estaba compuesto por dos cromosomas circulares de 2.961.146 pb y 1.072.314 pb.
-
Los investigadores informaron por primera vez que una nueva vacuna era eficaz contra las infecciones por estafilococos.
-
Científicos del Instituto Boyce Thompson de Nueva York anunciaron que han desarrollado con éxito la primera vacuna "comestible" contra el virus Norwalk que causa diarrea, en un paso que puede revolucionar la lucha contra las enfermedades en los países pobres.
-
Streptomyces coelicolor es un representante del grupo de bacterias filamentosas, viven en el suelo responsable de producir la mayoría de los antibióticos naturales utilizados en la medicina humana y veterinaria
-
Zyvoxid® (linezolid, en sus presentaciones por vía intravenosa, comprimidos y suspensión oral) para el tratamiento de infecciones causadas por bacterias gram-positivas. Se trata del primer antibiótico de la nueva clase de las oxazolidinonas, la primera clase completamente nueva de antibióticos desarrollada en los últimos 35 años.
-
Aparece en Asia la gripe Aviar, producido por el subtipo HSN1 del virus Influenza A
-
Los Investigadores en el Centro Médico de la Universidad de Columbia han decodificado el genoma del pneumophila de Legionella, las bacterias responsables de la enfermedad de Legionarios, y han encontrado algunas sorpresas en los genes del fallo de funcionamiento 3.000.
-
Conocimiento del genoma de este microorganismo productor del antibiótico eritromicina
-
El 29 de abril de 2009 el mundo despertó con la noticia de que la influenza AH1N1 era nombrada pandemia por la Organización Mundial de la Salud (OMS)
-
El género Mycobacterium está formado por bacilos aerobios inmóviles, algunos de los cuáles son patógenos que causan graves enfermedades en los mamíferos, incluyendo tuberculosis y lepra.
De modo que el descubrimiento de su proceso de esporulación es un avance para conocer como producen las enfermedades y como atacar a este género de bacterias. -
Nuevo brote de Ebola genera la necesidad de buscar un tratamiento, siendo este brote el de mayor numero de fallecidos 11,300
-
Daniel G. Nocera, profesor de Harvard crea una versión genéticamente modificada de Ralston eutropha que es capaz de degradar el CO2 atmosférico y transformarlo en ATP
-
El ántrax ha resurgido del hielo y se ha propagado entre la población siberiana. El calentamiento global ha posibilitado, con temperaturas hasta doce grados superiores a la media de estos últimos años, el deshielo de los cadáveres de varios renos infectados en 1941, en plena guerra mundial, y la bacteria ha despertado de su letargo.
Looking for a timeline maker?
Create timelines for projects, roadmaps, history, lessons, legal cases, and stories with Timetoast. Timetoast is a timeline maker for work, school, research, and stories.